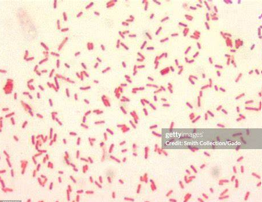
<p><u>Kleine</u> gramnegatieve staven tot coccobacillaire vormen! </p>
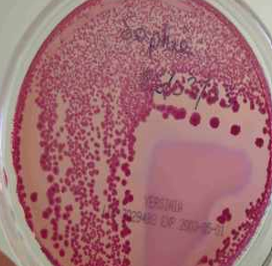
<ul><li><p>Groei op alle algemene bodems</p></li><li><p>Groei op MC met kleurloze kolonies (lactosenegatief) (kleine kolonies na 24 uur)</p></li><li><p>Groei op SS-agar met kleurloze kolonies (lactosenegatief)</p></li><li><p>Groei op CIN-agar met kolonies die een rood centrum en heldere perifere zone vertonen na 48 uur incubatie (mannitol positief) </p></li><li><p>Facultatief aeroob</p></li></ul><p></p>
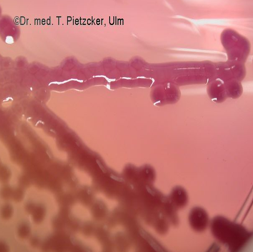
<ul><li><p>groei op alle algemene bodems </p></li><li><p>groei op MC met roze slijmerige kolonies (lactosepositief) </p></li><li><p>facultatief aeroob</p></li></ul><p></p>
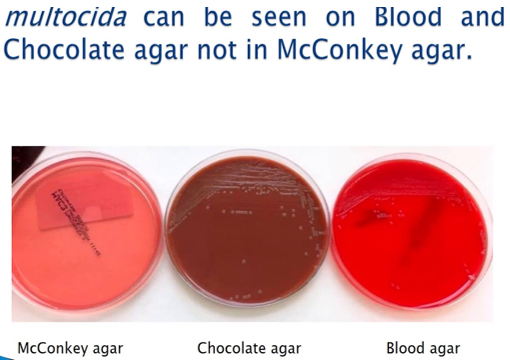
<ul><li><p>groei op bloedagar met kleine, niet-hemolytische, doorschijnende kolonies na 24u incubatie </p></li><li><p>geen groei op MC ! </p></li><li><p>Facultatief aeroob </p></li></ul><p></p>

1/76
Looks like no tags are added yet.
Name | Mastery | Learn | Test | Matching | Spaced | Call with Kai |
|---|
No analytics yet
Send a link to your students to track their progress
Bespreek het voorkomen van het geslacht Escherichia.
Escherichia coli of colibacillen behoren tot de commensale darmflora van mens en dier.
Bespreek het algemeen pathogeen vermogen van E. coli.
Frequente oorzaak van cystitis, septicemie, wondinfectie, meningitis, galblaasontsteking …
Indien ze talrijk voorkomen op mucosa of in secreties waar ze normaal niet voorkomen (steriele lokaties, zoals de vagina of de keel) kunnen ze dus een pathogene rol spelen. Hierbij gaat het meestal enkel om kolonisatie, maar soms is er ook sprake van een echte infectie.
Sommige serotypes kunnen diarree veroorzaken.
Bespreek het pathogeen vermogen van EHEC.
EHEC = enterohemorrhagische E. coli
STEC (Shiga-toxine producerende E. coli)
Meer dan 150 serotypes, waarvan de belangrijkste: O157:H7
Leidt tot hemorrhagische colitis of bloederige diarree (vnl. na het eten van een hamburger)
Bij ongeveer 8% van de patiënten kan het hemolytisch uremisch syndroom (HUS) ontstaan (hemolytische anemie, trombocytopenie en acuut nierfalen) vanwege schade aan het vasculair endotheel na absorptie van de Shiga-toxine ter hoogte van de darmen
HUS treedt meestal 1 week na de start van de diarree op, wanneer het serotype reeds verdwenen is uit de feces
HUS kan bevorderd worden door antibiotica (lyse bacteriën en vrijgave toxine) en darm-motiliteitsremmers (verhoogde kans op toxine-absorptie)
Bespreek het pathogeen vermogen van EPEC.
EPEC = enteropathogene E. coli
20-tal serotypes
Epidemische diarree bij kinderen <2j
Adhesie aan de epitheelcellen door EAF-plasmide (E. coli adherence factor)
Bespreek het pathogeen vermogen van ETEC.
ETEC = enterotoxigene E. coli
20-tal serotypes
Reizigersdiarree (turista) = waterige diarree tgv. productie van exotoxine(n)
Bespreek het pathogeen vermogen van EIEC.
EIEC = enteroinvasieve E. coli
10-tal serotypes
Invasieve, dysenterische vorm van diarree door binnendringen in het epitheel
Bespreek het pathogeen vermogen van enteroadhesieve E. coli.
Enteroadhesieve E. coli:
EAggEC = aggregerende
DAEC = diffuus adherent
Serotypes die niet klasseerbaar zijn in de andere groepen en waarvan de klinische betekenis nog onduidelijk is.
Bespreek de isolatie van E. coli.
Groei op alle algemene bodems
Groei op MC met rode-roze kolonies (lactosepositief), vaak met galzoutenneerslag
Facultatief aeroob
Bespreek de identificatie van E. coli op vlak van gramkleuring, glucosefermentatie, oxidase, aeroob/anaeroob, Kligler-type, MIU, FAD (TDA), MR-VP, DNase, citraat en bèta-glucuronidase.
Gramnegatieve staven, glucose fermenterend, oxidasenegatief en facultatief aeroob (lactosepositief)
Kligler-type: coli- of paracoli-type (+++- of ++—)
MIU: + + -
FAD (TDA): -
MR-VP: + / -
DNase: -
citraat: -
bèta-glucuronidase: + (95%) (specifiek bij het geslacht Escherichia en een deel van het geslacht Shigella)
Wat zijn de uitzonderingen bij de identificatie van E. coli?
sommige stammen produceren geen gas = anaerogene coli
sommige stammen zijn onbeweeglijk (negatief voor motiliteit)
bij serotypes die diarree kunnen veroorzaken, kunnen afwijkende biochemische eigenschappen voorkomen, deze kunnen vaak geïdentificeerd worden mbv. antisera
Bespreek de isolatie en identificatie van EHEC.
EHEC = enterohemorrhagische E. coli
Isolatie:
Sorbitol MAC (MC) (SMAC): O157-stammen zijn sorbitolnegatief en overige E. coli zijn sorbitolpositief
Identificatie:
Vaak afwijkende kenmerken, waaronder bèta-glucuronidasenegatief
Serotypering mbv. antisera
Laattijdige diagnose → opsporen van antilichamen gericht tegen O157-lipopolysaccharide = kan behulpzaam zijn bij de diagnose van HUS
Bespreek de behandeling van E. coli.
De gevoeligheid van E. coli voor antibiotica is weinig voorspelbaar. Een antibiogram is meestal vereist.
Benoem de 4 subgroepen of soorten van het geslacht Shigella.
Shigella dysenteriae (15 serotypes)
Shigella flexneri (8 serotypes)
Shigella boydii (19 serotypes)
Shigella sonnei (1 serotype)
Wat is 1 van de belangrijkste eigenschappen bij Shigella bacteriën?
Het zijn onbeweeglijke Enterobacteriaceae!
Bespreek het voorkomen van het geslacht Shigella.
Pathogene darmparasiet bij de mens (uitzonderlijk bij dieren)
Bespreek het algemeen pathogeen vermogen van het geslacht Shigella.
Veroorzaken diarree:
Dysenterie (invasieve type, darminfectie doorgaans met bloed en slijm in de stoelgang)
Niet-bloederige diarree
Ernst van de diarree is gerelateerd aan de soort: Sh. dysenteriae > Sh. flexneri > Sh. boydii > Sh. sonnei
Zeldzame oorzaak van sepsis
Zeldzame complicatie = HUS door productie van Shiga-toxinen door Sh. dysenteriae
Bespreek de overdracht van het geslacht Shigella.
Feco-orale overdracht (persoon-persoon) of via gecontamineerd voedsel of water
Vnl. onder slechte hygiënische omstandigheden
Dysenteriae, flexneri en boydii komen vnl. voor in tropische streken
Sonnei komt vnl. voor in onze streken
Bespreek de isolatie van het geslacht Shigella.
Groei op alle algemene bodems
Groei op MC met kleurloze kolonies (lactosenegatief), vaak kleine kolonies na 24h incubatie
Groei op SS-agar met kleurloze kolonies (lactosenegatief) (sommige stammen van Sh. dysenteriae groeien evenwel niet op SS-agar)
Groei op XLD-agar met rode kolonies (lactose-, sucrose-, en xylosenegatief en ook geen lysinedecarboxylatie)
Facultatief aeroob
Bespreek de identificatie van het geslacht Shigella op vlak van gramkleuring, glucosefermentatie, oxidase, aeroob/anaeroob, Kligler-type, MIU, FAD (TDA), MR-VP, DNase, acetaat en mannitol.
Gramnegatieve staven, glucose fermenterend, oxidasenegatief en facultatief aeroob (lactosenegatief)
Kligler-type: shigella-type (+ - - -)
MIU: - ± - (onbeweeglijk!)
FAD (TDA): -
MR-VP: + / -
DNase: -
acetaat: - (in tegenstelling tot Escherichia)
mannitol: + (uitgezonderd Sh. dusenteriae)
Metabool weinig actief
Wat is er belangrijk bij de biochemische testen van Shigella?
Biochemisch vermoeden van Shigella dient steeds bevestigd te worden door serotypering. Deze laat toe de subgroep en het specifiek serotype te bepalen.
Bespreek de behandling van het geslacht Shigella.
Meestal gevoelig voor ampicilline, cotrimoxazole en fluorochinolonen.
toenemend aantal resistente stammen in ontwikkelingslanden → gevoeligheid wordt moeilijker te voorspellen en in deze gevallen is een antibiogram vereist
Hoeveel serotypes heeft de soort S. enterica binnen het geslacht Salmonella?
Meer dan 2000 serotypes
typhi, enteritidis, typhimurium, paratyphi A …
Bespreek het voorkomen van het geslacht Salmonella.
Pathogene parasiet van mens, zoogdieren, vogels en koudbloedigen.
Menselijke serotypes: typhi, paratyphi A, B en C → enkel bij de mens
Zoönotische serotypes: enteritidis, typhimurium, dublin … → komen vnl. voor bij dieren maar kunnen soms ook infecties teweegbrengen bij de mens
Dierlijke serotypes: enkel bij dieren
Bespreek de overdracht van menselijke en zoönotische serotypes bij het geslacht Salmonella.
Menselijke serotypes:
feco-oraal contact (persoon-persoon) of via gecontamineerd voedsel en water → lage infectieuze dosis!
Zoönotische serotypes:
Via gecontamineerd voedsel (van dierlijke oorsprong, zoals kippeneieren)
Via direct contact met dieren
Bespreek het pathogeen vermogen van menselijke en zoönotische serotypes bij het geslacht Salmonella.
Menselijke serotypes:
tyfus en paratyfus ((para)tyfeuze koorts)
kiemdrager
Zoönotische serotypes:
gastro-enteritis
sepsis (zeldzaam)
kiemdrager
Bespreek de tyfus, de paratyfus en het kiemdragerschap bij de menselijke serotypes van het geslacht Salmonella.
Incubatietijd = 5-10 dagen - 6 weken
Symptomen:
Begint met ziektegevoel (malaise), daarna geleidelijk oplopende hoge koorts.
Na 1 week is de patiënt suf en traag, heeft deze vage buikpijn en algemene uitputting.
Zeer ernstige ziekte met een mortaliteit van ongeveer 10% zonder antibioticumbehandeling, en een mortaliteit van <1% met antibioticumbehandeling.
Na het doormaken van de ziekte kunnen deze serotypes achterblijven in de galblaas → chronische kiemdragerschap
Onze streken: uitsluitend importpathologie (vanuit ontwikkelingslanden)
Bespreek de gastro-enteritis, de sepsis, en het kiemdragerschap, bij de zoönotische serotypes van het geslacht Salmonella.
Gastro-enteritis
incubatietijd: 2-tal dagen
symptomen: diarree, meestal met bloed en slijm, en bijmenging van WBC, ook koorts en abdominale krampen
Sepsis (zeldzaam)
vnl. bij personen met een verminderde weerstand
Hierbij kunnen infecties op afstand ontstaan: osteomyelitis, artritis, pneumonie…
Kiemdragerschap
in principe slechts voor enkele weken
kan langer zijn bij oa. behandeling met antibiotica, jonge en oude leeftijd, hypochloorhydrie of achloorhydrie, aanwezigheid van galstenen
Bespreek de isolatie van het geslacht Salmonella.
Groei op alle algemene bodems
Groei op MC met kleurloze kolonies (lactosenegatief)
Groei op SS-agar met kleurloze kolonies met zwart centrum (lactosenegatief en H2S-positief)
Groei op XLD-agar met rode kolonies (met zwart centrum) (lactose-, sucrose-, en xylosepositief maar ook lysinedecarboxylatie, en H2S-positief)
Facultatief aeroob
(Foto → SS-agar)

Bespreek de identificatie van het geslacht Salmonella op vlak van gramkleuring, glucosefermentatie, oxidase, aeroob/anaeroob, Kligler-type, MIU, FAD (TDA), MR-VP, DNase, citraat, ONPG en lysine-decarboxylatie.
Gramnegatieve staven, glucose fermenterend, oxidasenegatief en facultatief aeroob (lactosenegatief en H2S positief)
Kligler-type: salmonella-type (+ (+) - +) → paratyphi A is wel H2S negatief en typhi vertoont weinig H2S productie, en ook geen gasproductie
MIU: + - -
FAD (TDA): -
MR-VP: + / -
DNase: -
citraat: + (-)
ONPG (bèta-galactosidase): -
Lysine-decarboxylatie: +
Wat is er belangrijk bij de biochemische testen van Salmonella?
Biochemisch vermoeden van Salmonella dient steeds bevestigd te worden door serotypering.
Bespreek de mogelijke antigenen bij Salmonella (serotypering).
Somatisch O-antigeen → onderverdeling in verschillende groepen: A, B, C1, C2, D, E1…
Flagellair H-antigeen
Kapselantigeen = Vi-antigeen → enkel bij typhi (zeldzaam positief bij paratyphi, dublin en sommige Citrobacter stammen)
Bespreek kort hoe de serotypering van Salmonella verloopt.
Agglutinatie met polyvalent O-antiserum
Indien positief → agglutinatie met specifieke O-groep antisera: D, B…
Daarna kan eventueel het H-antigeen opgespoord worden
En eventueel het Vi-antigeen bij vermoeden van typhi
Verdere serotypering gebeurt in referentielabo’s
Bespreek de serotypering van S. enterica typhi.
O-antigeen met groep D antisera
H-antigeen met anti-d
Vi-antigeen met anti-Vi
Als het Vi-antigeen zeer sterk is, wordt het O-antigeen soms gemaskerd
Opkoken bacteriesuspensie gedurende 15 minuten en vervolgens hertesten met O-antisera
Berspreek de WIDAL-test voor Salmonella.
De WIDAL-test is een test die antistoffen (of agglutininen) opspoort, die gericht zijn tegen de O, H, en Vi-antigenen, in het serum (bloed).
Echter leidt het vaak naar valse positieve en valse negatieve resultaten, waardoor geen definitieve diagnose mogelijk is.
Enkel nuttig bij verdenking op tyfus.
Meestal pas ± 1 week na de infectie aantoonbaar.
Antistoffen tegen Vi-antigenen verdwijnen normaal na genezing, maar blijven aanwezig bij chronische dragers → belangrijk voor de sceening naar chronisch dragerschap
Bespreek de behandeling van het geslacht Salmonella.
Niet-gecompliceerde gastro-enteritis
NIET behandelen met antibiotica aangezien deze het dragerschap kunnen verlengen
Tyfus en paratyfus
WEL behandelen met antibiotica = BELANGRIJK (mortaliteit <1% ipv 10%)
Gevoeligheid = weinig voorspelbaar → antibiogram is meestal vereist
Bespreek de preventie van tyfus.
Vaccinatie tegen tyfus
Vivotif → obv. levend verzwakte typhi stam, orale inname (3 maal 1 capsule met 2 dagen interval)
Benoem 3 pathogene soorten binnen het geslacht Yersinia (in het totaal 10-tal soorten).
Yersinia enterocolitica
Yersinia pseudotuberculosis
Yersinia pestis
Wat kan er gezegd worden over Y. frederiksenii en Y. kristensenii?
Dit zijn niet-pathogene soorten binnen het geslacht Yersinia.
Bespreek het voorkomen van Y. enterocolitica, pseudotuberculosis en pestis.
Enterocolitica = parasiet van varkens en runderen en wordt via voedsel (rauw vlees) overgebracht op de mens
Pseudotuberculosis = parasiet van varkens, vogels en andere in het wild levende dieren.
Pestis = parasiet van knaagdieren die via beten van rattenvlooien op de mens kan worden overgezet
Bespreek het pathogeen vermogen van Y. enterocolitica.
Oorzaak van gastro-enteritis
incubatietijd= 4-7 dagen
slepend verloop bij jonge kinderen (2-4 weken!)
abdominale pijn, kolieken, koorts en braken bij oudere kinderen en volwassenen (pseudo-appendiculair syndroom)
onze streken: vnl. serotype O:3, minder serotype O:9, zeldzaam andere serotypes
associatie met het eten van rauw varkensvlees (rauw gehakt, varkenstongen…)
Zeldzaam sepsis
belangrijke risicofactoren: hemochromatose, gedaalde afweer (oa. verminderde fagocytose), toegenomen virulentie van de bacterie
via bloedtransfusie door mogelijke groei van Y. enterocolitica bij koelkasttemperatuur en stimulatie van de groei door exogeen ijzer (bloedzakken)
Post-infectieuze complicaties
reactieve artritis tgv. neerslag Ag-AL complexen in de verschillende gewrichten: enkele dagen tot 1 maand na start van de diarree, bij 10-30% van de volwassenen, symptomen duren gemiddeld 1-4 maanden
erythema nodosum tgv. neerslag Ag-AL complexen in de oppervlakkige arteriolen

Bespreek het pathogeen vermogen van Y. pseudotuberculosis.
Mesenteriale lymfadenitis
vergroting en abcedatie (toenemende zwelling met toenemende pijn) van de lymfeklieren in de ileocaecale streek
acuut pijnsyndroom gelijkend appendicitis = pseudo-appendicitis
Bespreek het pathogeen vermogen van Y. pestis.
Verwekker van de pest
nog enkele haarden in Z. Amerika, Afrika en V. Oosten
niet meer in onze streken
potentieel gevaar → biologische oorlogsvoering met verspreiding via de aerogene weg
Bespreek de gramkleuring van het geslacht Yersinia.
Kleine gramnegatieve staven tot coccobacillaire vormen!
Bespreek de isolatie van het geslacht Yersinia.
Groei op alle algemene bodems
Groei op MC met kleurloze kolonies (lactosenegatief) (kleine kolonies na 24 uur)
Groei op SS-agar met kleurloze kolonies (lactosenegatief)
Groei op CIN-agar met kolonies die een rood centrum en heldere perifere zone vertonen na 48 uur incubatie (mannitol positief)
Facultatief aeroob
Bespreek de identificatie van het geslacht Yersinia op vlak van gramkleuring, glucosefermentatie, oxidase, aeroob/anaeroob, Kligler-type, MIU, FAD (TDA), MR-VP, DNase.
Gramnegatieve staven, glucose fermenterend, oxidasenegatief en facultatief aeroob (lactosenegatief)
Kligler-type: Shigella-type (+ - - -)
MIU: + +(-) -
Y. enterocolitica: indol +(-), Y. pseudoturberculosis: indol -
Beweeglijk bij 22-30°C, vaak onbeweeglijk bij 37°C
FAD (TDA): -
MR-VP: + / -
DNase: -
Wat is er belangrijk bij de biochemische testen van Yersinia enterocolitica?
Biochemisch vermoeden van Yersinia enterocolitica dient steeds bevestigd te worden door serotypering, temeer omdat een aantal serotypes (wellicht) niet pathogeen zijn.
In onze streken zijn voornamelijk serotype O3 en O9 de belangrijkste pathogene serotypes.
Bespreek de serologische diagnostiek bij Yersinia enterocolitica.
Speelt een belangrijke rol bij het vaststellen van post-infectieuze complicaties van Y. enterocolitica → bacterie is in deze gevallen vaak niet meer kweekbaar aangezien de gastro-intestinale infectie dan meestal al voorbij is
Twee manieren:
Opsporen van antistoffen (agglutininen, IgM (en IgG)) tegen celwandpolysacchariden (LPS, O-antigenen): positief kort na de acute fase van een infectie, maar na enkele maanden terug negatief
Opsporen van antistoffen ten opzichte van Yersinia outer proteins (YOPs) met behulp van immunoblot technieken → gevoeliger en specifieker, vnl. bij post-infectieuze complicaties, antistoffen blijven langer aantoonbaar dan agglutininen (IgA, IgG)
Bespreek de behandeling van Yersinia enterocolitica en Y. pseudotuberculosis.
Y. enterocolitica = meestal zelflimiterend en geen antibiotica-therapie vereist
Cotrimoxazole en doxycycline → bij ernstige gevallen
Y. enterocolitica O3 en O9: ampicilline R
Y. pseudotuberculosis: ampiciline S
Nut van antibiotica bij artritis = niet duidelijk (eventueel wel nut door eliminatie van Y. enterocolitica in de mesenterische lymfeknopen → verkort mogelijks het beloop?)
Wat is er in het algemeen bijzonder aan de geslachten Proteus, Morganella en Providencia.
Zijn sterk verwante geslachten
Deze geslachten zijn in staat om fenylalanine en tryptofaan te desamineren → FAD (TDA) positief !!! (= vrijwel unieke eigenschap binnen de familie van de Enterobacteriaceae)
Bespreek het algemeen voorkomen van de geslachten Proteus, Morganella en Providencia.
Saprofieten in de omgeving
Transiënte darmflora
Bespreek het pathogeen vermogen van Proteus mirabilis en Proteus vulgaris.
P. mirabilis = frequente oorzaak van urineweginfecties (cystitis) en speelt een rol bij niersteenvorming (door hun sterke urease-activiteit worden ammoniak en CO2 in de urine gevormd → pH-verandering → niersteenvorming)
P. vulgaris (Morganella morganii en Providencia spp.) komen meer voor als “opportunistische” pathogenen in het ziekenhuismilieu
Sepsis
Wondinfecties
…
Bespreek de isolatie van de geslachten Proteus, Morganella en Providencia.
Groei op alle algemene bodems
Groei op MC met kleurloze kolonies (lactosenegatief)
Proteus spp. zwermen uit op de meeste vaste voedingsbodems (niet op voedingsbodems met verlaagde elektrolytenconcentraties) (zeer scherpe geur)
Facultatief aeroob

Bespreek de identificatie van het geslacht Proteus op vlak van gramkleuring, glucosefermentatie, oxidase, aeroob/anaeroob, Kligler-type, MIU, FAD (TDA), MR-VP, DNase.
Gramnegatieve staven, glucose fermenterend, oxidasenegatief en facultatief aeroob (lactosenegatief)
Kligler-type: Salmonella type (+ (+) - +)
MIU: mirabilis + - +, vulgaris + + +
FAD (TDA): +
MR-VP: + / -
DNase: -
Bespreek de behandeling van de geslachten Proteus, Morganella en Providencia.
Gevoeligheid is weinig voorspelbaar → een antibiogram is meestal vereist
P. mirabilis = meestal ampicilline S, 1ste en 2de generatie cefalosporines S
P. vulgaris (Morganella morganii en Providencia spp.) = meestal ampicilline R, 1ste en 2de generatie cefalosporines R
Welke twee soorten zijn belangrijk binnen het geslacht Klebsiella?
K. pneumoniae en K. oxytoca
Bespreek het voorkomen van het geslacht Klebsiella.
Behoort tot de commensale darmflora van de mens (minder talrijk dan E. coli) en de bovenste luchtwegen
Bespreek het pathogeen vermogen van Klebsiella.
Oorzaak van: urineweginfecties, pneumonie (vnl. K. pneumoniae), sepsis…
K. oxytoca veroorzaakt voornamelijk infecties bij patiënten met een verminderde weerstand (opportunistische infecties)
Bespreek de isolatie van het geslacht Klebsiella.
groei op alle algemene bodems
groei op MC met roze slijmerige kolonies (lactosepositief)
facultatief aeroob
Bespreek de identificatie van het geslacht Klebsiella op vlak van gramkleuring, glucosefermentatie, oxidase, aeroob/anaeroob, Kligler-type, MIU, FAD (TDA), MR-VP, DNase.
Gramnegatieve staven, glucose fermenterend, oxidasenegatief en facultatief aeroob (lactosepositief)
Kligler-type: Coli-type (+ + + -) of Paracoli-type (+ + - -)
MIU: oxytoca - + +, pneumoniae - - + (onbeweeglijk!)
FAD (TDA): -
MR-VP: - / + !!!
DNase: -
Bespreek de behandeling van het geslacht Klebsiella.
Veel resistentie-ontwikkeling op basis van verschillende resistentiemechanismen → praktisch altijd ampicilline resistent
Gevoeligheid is weinig voorspelbaar → een antibiogram is meestal vereist
Bespreek het voorkomen van het geslacht Serratia.
Saprofieten in de omgeving
Transiënte darmflora en flora van de bovenste luchtwegen
Bespreek het pathogeen vermogen van het geslacht Serratia.
Oorzaak van:
wondinfecties
pneumonie
urineweginfecties
sepsis
…
Opportunistische pathogenen (nosociomale infecties)
Bespreek de isolatie van het geslacht Serratia.
groei op alle algemene bodems
groei op MC met kleurloze kolonies (lactosenegatief)
facultatief aeroob
Bespreek de identificatie van het geslacht Serratia op vlak van gramkleuring, glucosefermentatie, oxidase, aeroob/anaeroob, Kligler-type, MIU, FAD (TDA), MR-VP, DNase, gelatinase.
Gramnegatieve staven, glucose fermenterend, oxidasenegatief en facultatief aeroob (lactosenegatief)
Kligler-type: Shigella-type (+ - - -)
MIU: oxytoca + - -
FAD (TDA): -
MR-VP: - / + !!!
DNase: + !!! (gelatinase +)
Bespreek de behandeling van het geslacht Serratia.
Zijn natuurlijk resistent tegen verschillende antibiotica, en verwerven snel resistentie tegen andere antibiotica, op basis van verschillende resistentiemechanismen
Gevoeligheid is weinig voorspelbaar → een antibiogram is meestal vereist
Geef 3 verschillende species die behoren tot het geslacht Pasteurella.
Pasteurella multocida
Pasteurella canis
Pasteurella dogmatis
Bespreek het voorkomen van het geslacht Pasteurella.
Commensaal van de bovenste luchtwegen bij in het wild levende dieren en huisdieren, vooral honden en katten → verwekker van pasteurellose (= hemorrhagische septicemie) bij dieren
Welke twee species binnen het geslacht Pasteurella veroorzaken de meeste humane infecties?
P. multocida (ongeveer 70%) en P. canis (ongeveer 20%)
De andere 10% van de infecties worden veroorzaakt door overige species.
Bespreek het pathogeen vermogen van het geslacht Pasteurella bij humane infecties.
Wondinfectie na honden- en/of kattenbeten en/of -krabben → vnl. door kattenbeten
snelle pijnontwikkeling
erytheem
zwelling
etter
Diepere (systemische) infecties kunnen ook voorkomen:
sepsis
osteomyelitis
artritis
meningitis
…
Bespreek de isolatie van het geslacht Pasteurella.
groei op bloedagar met kleine, niet-hemolytische, doorschijnende kolonies na 24u incubatie
geen groei op MC !
Facultatief aeroob
Bespreek de identificatie van het geslacht Pasteurella multocida op vlak van gramkleuring, glucosefermentatie, oxidase, aeroob/anaeroob, beweeglijkheid, urease, indool en mannitol.
Gramnegatieve staven, glucose fermenterend (gele stomp bij Kligler), oxidasepositief en facultatief aeroob
Oxidasepositief → oxidasereactie is vaak negatief of zwakker positief met het dimethylreagens, dan met het tetra-methyl-p-fenyleendiamine reagens, reactie wordt ook negatief beïnvloed door een zure pH (bijvoorbeeld bij Kligler)
Onbeweeglijk
Ureasenegatief (onderscheid met Actinobacillus ureae)
Indoolpositief (onderscheid met Actinobacillus ureae)
Mannitolpositief (onderscheid met Pasteurella canis)
(MIU → - + -)

Bespreek de behandeling van het geslacht Pasteurella.
Gevoelig voor penicilline, ampicilline, macroliden en fluorocinolonen
Zelzaam bèta-lactamase producerende stammen
Bespreek het voorkomen van Actinobacillus ureae.
Behoort tot de normale commensale flora van de bovenste luchtwegen bij de mens
Bespreek het pathogeen vermogen van Actinobacillus ureae.
Purulente bronchitis
Zeldzaam: sepsis, meningitis …
Bespreek de isolatie van Actinobacillus ureae.
groei op bloedagar met kleine, niet-hemolytische, slijmerige kolonies na 24u incubatie
geen groei op MC !
Facultatief aeroob
Bespreek de identificatie van Actinobacillus ureae op vlak van gramkleuring, glucosefermentatie, oxidase, aeroob/anaeroob, beweeglijkheid, urease, indool en mannitol.
Gramnegatieve staven (korte dikke staafjes), glucose fermenterend, oxidasepositief en facultatief aeroob
Onbeweeglijk
Ureasepositief (onderscheid met Pasteurella multocida)
Indoolnegatief (onderscheid met Pasteurella multocida)
Mannitolpositief (onderscheid met Pasteurella canis)

Bespreek de behandeling van Actinobacillus ureae.
Gevoelig voor penicilline en ampicilline.